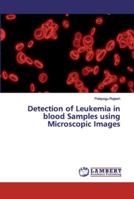
Detection of Leukemia in blood Samples using Microscopic Images 6200091625 Book Cover

Most Popular Books
- Biometrie-basiertes Sicherheitssystem für ein digitales Bild: unter Verwendung des AES-Algorithmus
- Water Waste Collecting Boat: Arduino Based Garbage Collector with Wireless Controller and Monitoring System for Water Waste
- Detection of Leukemia in blood Samples using Microscopic Images
- Sistema di sicurezza basato su biometria per un'immagine digitale
- A Security System for a Digital Camera